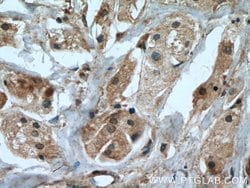
IGFBP5 Rabbit anti-Human, Mouse, Polyclonal, Proteintech 20 &mu;L; Unconjugated:Antibodies,

missing translation for 'onlineSavingsMsg'
Learn More
Learn More
IGFBP5 Rabbit anti-Human, Mouse, Polyclonal, Proteintech
Rabbit Polyclonal Antibody
Brand: Proteintech 55205-1-AP-20UL
This item is not returnable.
View return policy
Description
This antibody is specific to IGFBL5.
The insulin-like growth factor-binding proteins, or IGFBPs, are a family of homologous proteins that have co-evolved with the IGFs. They serve not only as shuttle molecules for the soluble IGFs, but also confer a level of regulation to the IGF signaling system. Physical association of the IGFBPs with IGF influences the bio-availability of the growth factors, as well as their concentration and distribution in the extracellular environment. In addition, the IGFBPs appear to have biological activity independent of the IGFs. Seven IGFBPs have thus far been described, each differing in their tissue distribution, half-lives and modulation of IGF interactions with their receptors. For instance, IGFBP1 is negatively regulated by insulin production. The IGFBP1 gene is expressed at a high level during fetal liver development and in response to nutritional changes and diabetes. It has been suggested that IGFBP2 functions as chaperone, escorting IGFs to their target tissues. It is expressed in several human tissues including fetal eye and fetal brain. IGFBP3 is the most abundant IGFBP and is complexed with roughly 80% of the serum IGFs. Both IGFBP3 and IGFBP4 are released by dermal fibroblasts in response to incision injury. IGFBP5 is secreted by myoblasts and may play a key role in muscle differentiation.Specifications
| IGFBP5 | |
| Polyclonal | |
| Unconjugated | |
| IGFBP5 | |
| IBP 5, IBP5, IGF binding protein 5, IGFBP 5, IGFBP5 | |
| Rabbit | |
| Antigen Affinity Chromatography | |
| RUO | |
| 16011, 3488 | |
| -20°C | |
| Liquid |
| Immunohistochemistry (Paraffin), Immunocytochemistry, Immunofluorescence, Western Blot | |
| 0.17 mg/mL | |
| PBS with 50% glycerol and 0.02% sodium azide; pH 7.3 | |
| P24593, Q07079 | |
| IGFBP5 | |
| Peptide | |
| 20 μL | |
| Primary | |
| Human, Mouse | |
| Antibody | |
| IgG |
Product Content Correction
Your input is important to us. Please complete this form to provide feedback related to the content on this product.
Product Title
Spot an opportunity for improvement?Share a Content Correction